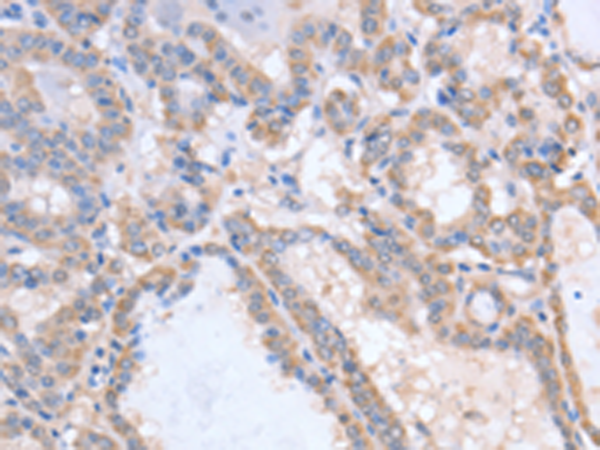

中文名稱:兔抗ACVR1C多克隆抗體
|
Background: |
ACVR1C is a type I receptor for the TGFB (see MIM 190180) family of signaling molecules. Upon ligand binding, type I receptors phosphorylate cytoplasmic SMAD transcription factors, which then translocate to the nucleus and interact directly with DNA or in complex with other transcription factors (Bondestam et al., 2001 [PubMed 12063393]). |
|
Applications: |
ELISA, IHC |
|
Name of antibody: |
ACVR1C |
|
Immunogen: |
Fusion protein of human ACVR1C |
|
Full name: |
activin A receptor, type IC |
|
Synonyms: |
ALK7; ACVRLK7 |
|
SwissProt: |
Q8NER5 |
|
ELISA Recommended dilution: |
1000-2000 |
|
IHC positive control: |
Human thyroid cancer |
|
IHC Recommend dilution: |
15-50 |
購(gòu)物車
購(gòu)物車 幫助
幫助
 021-54845833/15800441009
021-54845833/15800441009
